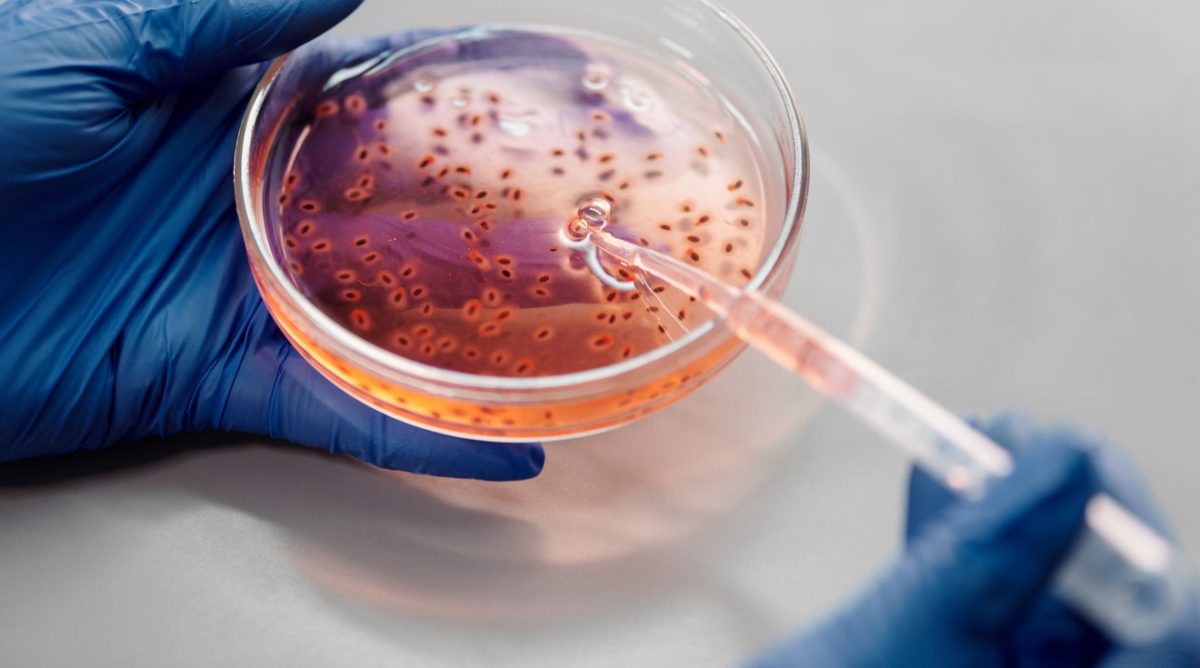

del Dr. Giuseppe Nacci
Nel 1979, a Laetoli, in Africa Orientale, Mary Leakey e Peter Jones scoprirono
impronte di Ominidi del tutto simili a quelle umane, poiché caratterizzate dal classico
arco plantare sollevato, dal tallone arrotondato e l’alluce rotondo e sporgente,
indispensabile per camminare in posizione eretta: erano a tutti gli effetti veri Esseri
umani.
Il test Potassio-Argon li radio-datava ad oltre Tre Milioni e mezzo di anni fa.
Mary Leakey, così scriveva:
“Almeno 3.600.000 anni fa, nel Pliocene, quello che io considero il diretto
progenitore dell’Uomo era un Bipede in grado di camminare perfettamente in
posizione eretta, e la forma del suo piede era identica a quella del nostro…
Dando ragione a Mary Leakey, che evidenziava presenza di Ominidi sulla Terra già
tre Milioni e mezzo di anni fa, la necessaria e precedente separazione tra Scimpanzè e
Uomo, basata unicamente su criteri morfologici, risulterebbe pertanto spostata molto più indietro nel tempo, addirittura ad oltre 12-15 Milioni di anni fa, cioè nel Miocene Medio, secondo molti Studiosi.
Ma tutto ciò sembra essere apparentemente in contrasto con gli attuali Studi di
Genetica molecolare del DNA umano e del DNA della Scimmia, pur accettando
l’ipotesi di una lontana derivazione della Specie umana da quella dello Scimpanzè.
Le possibili origini della specie umana
In merito alla possibile origine della Specie umana come derivata da quella dello
Scimmia, possiamo leggere materiale utile da diversi Testi scientifici di Biologia
Molecolare, vecchi anche di quarant’anni, come ad esempio quello del grande
Giorgio Mangiarotti, dove possiamo trarre diversi spunti di riflessione (Giorgio
Mangiarotti: Lineamenti di Biologia, UTET, 1978, Unione Tipografico-Editrice Torinese, Capitolo
35: Evoluzione molecolare ed evoluzione biologica, pagg.: 725-766; Evoluzione della mioglobina e
dell’emoglobina, pagg.:767-786).
Provando allora a classificare l’Uomo e lo Scimpanzè in base a criteri puramente morfologici, considerando cioè parti diverse dello scheletro dell’Uomo umano e dello
scheletro dello Scimmia, che vengono così misurate ed espresse in termini di
lunghezze relative, arriviamo al fatto incontestabile che “…la differenza media nelle
proporzioni corporee dell’Uomo e dello Scimpanzè risulta essere non solo maggiore
di quella fra Famiglie diverse, ma addirittura ad un Sotto-Ordine diverso…” (Giorgio
Mangiarotti: Lineamenti di Biologia, UTET, 1978, Unione Tipografico-Editrice Torinese, Capitolo
35: Evoluzione molecolare ed evoluzione biologica, pagg.: 760).

DNA umano e di scimmia a confronto
Ma tutto questo è in forte disaccordo sui dati di confronto fra DNA umano e DNA di
Scimmia. Sappiamo infatti che, a livello di sequenze molecolari, Uomo e Scimpanzè risultano
essere straordinariamente simili.
Per quanto riguarda le Proteine, le loro sequenze genetiche, basate su un certo
numero di Aminoacidi, esaminate sia nell’Uomo che nello Scimpanzè, sono identiche
fra loro al 99%. Soltanto 19 sequenze di Aminoacidi su 2.633 sequenze totali esaminate risultano
essere sostituite in qualche loro parte da un altro Aminoacido.
Di questi Aminoacidi, almeno nove risultano essere i più importanti:
- Leucina
- Valina
- Isoleucina
- Lisina
- Metionina
- Triptofano
- Treonina
- Fenilalanina
- Istidina
Ne consegue che la distanza genetica tra queste 2 Specie, in base ai pattern
elettroforetici di sequenze di Aminoacidi, è quindi bassissima, pari a quella
intercorrente fra Specie gemelle.
Ciò però è in forte disaccordo con la classificazione morfologica, che considera
l’Uomo e lo Scimpanzè non solo appartenenti a Specie NON gemelle, ma addirittura a
Sotto-Ordini diversi, separatisi fra loro almeno 12-15 Milioni di anni fa.
Vi è quindi un notevole contrasto tra l’Evoluzione biologica, che determina l’Aspetto
esteriore, la Postura, la Locomozione e i mezzi di comunicazione dell’Essere vivente
e, viceversa, l’Evoluzione molecolare, basata quest’ultima sul semplice studio de
DNA, e quindi sul profilo proteico dell’Albumina, dell’Emoglobina e di altre
molecole proteiche, e che determina poi la separazione delle Linee evolutive
dell’Uomo e dello Scimpanzè.
Il processo evolutivo e la differenza morfologica
Lo Studio evolutivo dei profili proteici dell’Albumina, della Mioglobina, e di altre
Proteine è un sistema di analisi dei dati molto sicuro, la cui corrispondenza alla realtà
è certa. Quindi è un ottimo sistema per studiare i processi evolutivi, poiché negli ultimi 120
Milioni di anni la modifica, cioè la Mutazione, delle Proteine è stata sempre costante
nel tempo. Naturalmente, ogni Proteina evolve, cioè muta, nel corso del tempo, e con velocità
diversa rispetto alle altre Proteine, e di questo gli Studiosi devono sempre tenerne
conto.
Il DNA e i profili proteici dell’Albumina, dell’Emoglobina, della Mioglobina e di
altre Proteine conducono comunque a porre Scimpanzè e Uomo molto distanti dalle
altre forme di vita e, viceversa, molto vicini fra loro.
Il fatto strano è però che tale vicinanza è incompatibile sotto l’aspetto morfologico.
Secondo il profilo genetico, Uomo e Scimpanzè sarebbero infatti Specie gemelle, con
il 99% del loro patrimonio genetico simile, e risulterebbero quindi due entità
genetiche separatesi molto di recente, vale a dire 5 Milioni di anni fa.
Ma secondo il profilo morfologico, cioè in base all’Aspetto fisico, le differenze sono
molto forti e, pertanto, la separazione fra Scimpanzè e Uomo risulterebbe molto più
antica di quanto calcolato sulla semplice differenza genetica, che risulta invece quasi
nulla.
Dando ragione a Mary Leakey, la separazione tra Scimpanzè e Uomo, basata
unicamente su criteri morfologici, viene oggi spostata molto più indietro nel tempo,
fino ad oltre 12-15 milioni di anni fa, cioè nel Miocene Medio, entrando quindi in
diretto conflitto con la data di separazione posta dal profilo genetico delle Proteine,
quest’ultima stimabile ad un’Epoca molto più recente, pari a circa 5 Milioni di anni
fa.
Differenza cromosomica tra uomo e scimmia
La soluzione di questo apparente paradosso potrebbe venire soltanto partendo dal
fatto di riconsiderare da capo lo studio di confronto dei due diversi DNA, cioè fra
quello dello Scimpanzè e quello dell’Uomo, ipotizzando la presenza di specifiche e
mirate modifiche genetiche apportate deliberatamente sul DNA.
Osservando così il DNA dello Scimpanzè, riscontriamo che esso ha ben 48
Cromosomi, come il resto tutte le altre Scimmie.
Viceversa, il DNA dell’Uomo ha soltanto 46 Cromosomi, pur avendo il profilo
proteico di migliaia di Proteine sostanzialmente identico a quello della Scimmia.
In particolare, si osserva che la coppia dei Cromosomi umani definiti come Numero
Due A e come Numero Due B risulti essere notevolmente simile alle due coppie di
Cromosomi 12 A e 13 A e 12 B e 13 B dello Scimpanzè, come se in qualche modo
singoli Cromosomi 12 e 13 si fossero fusi fra loro in un singolo Cromosoma più
grande, diventando così il Cromosoma umano etichettato come “Numero Due”.
In sostanza Esso sarebbe la reliquia di un antichissimo Telomero nato dalla fusione, e
questo segnerebbe allora il punto in cui il Cromosoma Numero 12 e il Cromosoma
Numero 13 della Scimmia vennero fusi fra loro per dare origine al Cromosoma
umano definito come Numero Due (Fan: Gene content and function of the Ancestral
Chromosome fusion site in Human Chromosome 2q13-2q14 and Paralogous Regions, Genome
Research Vol. 12, Laboratory Press, Cold Spring Harbor, pp: 1663-1672 )
Mutazioni genetiche, cromosomiche e apoptosi
Studiando poi l’intero DNA umano, sono riscontrabili altre precise Inversioni e
Traslocazioni cromosomiche (mutazioni genetiche), stranamente ancora compatibili
con la vita e tali da non aver determinato il meccanismo di Apoptosi (suicidio) del
DNA stesso.
Il motivo per cui tale meccanismo scatta nelle cellule può essere sostanzialmente
imputabile alla presenza di danno o rottura del DNA (Acido Desossiribo-Nucleico),
definibile come Aberrazione cromosomica, cromatidica o sub-cromatidica.
Il filamento di DNA, gravemente compromesso nella sua struttura, attiva quindi il
proprio ordine di suicidio grazie alla presenza di banali Vitamine che, come previsto
dalle Leggi di Natura, tendono a far funzionare al meglio, come vere e proprie
“Chiavi della Vita”, le complesse reazioni biochimiche che sovraintendono al corretto
funzionamento della singola cellula, in ogni sua forma e fase di sviluppo.
L’Apoptosi è ben evidente negli Aborti spontanei che colpiscono circa il 9% di tutti i
tentativi di gravidanza della donna (UNSCEAR, 1988), Aborti che presentano sempre
evidenza di grossolane Aberrazioni cromosomiche.
Per Apoptosi si intende quindi l’auto-attivazione di Endonucleasi specifiche che
frammentano il DNA, agendo a livello di Siti nucleosomiali costituenti l’unità
strutturale primaria della Cromatina nucleare (DNA) della cellula.
Le molecole d’induzione attivano quindi gli Enzimi proteolitici intracellulari, che
provocano allora degradazione per proteolisi delle sequenze vitali del DNA.
Nell’Apoptosi i granuli compatti del DNA frammentato (tratti di DNA internucleosomale), ridotto cioè in piccoli frammenti, vengono spostati alla periferia della cellula morente, formando una caratteristica figura a mezzaluna.
Questi frammenti vengono poi circondati dalla membrana della stessa cellula ed
evaginati all’esterno, conferendo alla stessa cellula un aspetto a bolle (Blebbing).
Queste bolle si staccano poi dalla cellula ormai morente dando così origine ai “Corpi
apoptosici”, ricchi di proteine transglutaminate, che vengono fagocitati dai Macrofagi
(Globuli Bianchi “spazzini”).
Una mutazione genetica compatibile con la vita
La stessa cellula, morente, espone poi alla sua superficie dei residui di FosfatidilSerina, che la segnala anch’essa come bersaglio ai Macrofagi per la sua successiva
fagocitosi. Osservando quindi, nel DNA umano, queste precise, antichissime Inversioni e
Traslocazioni cromosomiche (mutazioni genetiche), e che stranamente furono ancora
compatibili con la vita e tali da non aver determinato il meccanismo di Apoptosi,
possiamo affermare che Esse avvennero verosimilmente in un’Epoca molto vicina
alla nostra, perché non diedero tempo alle Proteine umane di differenziarsi da quelle
dello Scimpanzè, come sarebbe dovuto avvenire nella normale Evoluzione temporale
presa in un arco di tempo di quindici o venti Milioni di anni, essendo questo il
periodo di tempo ritenuto accettabile per giustificare la profonda differenziazione
morfologica osservabile fra le due Specie, ben evidente dal punto vista scheletrico, e
fisico-comportamentale.
Ci saremmo quindi aspettati un identico, graduale, lento e progressivo processo di
modifica genetica anche delle singole catene proteiche che compongono una qualsiasi
delle tante molecole proteiche presenti nell’Uomo e nello Scimpanzè, come a
esempio l’Emoglobina, l’Insulina, o la Ferritina, permettendoci così di costruire
perfettamente le loro Linee evolutive analogamente a quanto compiuto con tutti gli
altri organismi viventi, dai Pesci e dagli Anfibi fino ai Rettili, agli Uccelli e ai
Mammiferi, con analoga corrispondenza anche dei rispettivi “Alberi evolutivi” basati
sulla semplice conformazione strutturale fisica degli animali considerati.

Ma nel caso dello Scimpanzè e nel caso dell’Uomo troviamo che tutte le sequenze
proteiche di tutte le Proteine, dall’Emoglobina alla Insulina alla Ferritina, risultano
essere assurdamente uguali.
“Qualcosa” modificò il DNA della Scimmia in ben precisi punti cromosomici, senza
arrecare danno all’organismo vivente derivante, e tutto questo meno di Cinque
Milioni di anni fa…
Il tassello mancante
Approfondendo ancora i dati in nostro possesso, notiamo poi che, stranamente, il
Genoma umano contenga ben 223 geni che non sono presenti nella Linea genetica
evolutiva del DNA delle Scimmie e degli altri mammiferi (Science, No. 291), e non è
noto come la Razza umana abbia potuto acquisire le importanti funzioni fisiologiche
e cerebrali che le sono peculiari, dal momento che la differenza tra Uomo e
Scimpanzè è di soli 300 geni, fra cui questi 223 geni che non sono presenti in altre
forme di vita terrestri. (Nature No. 409).
Avendo studiato per oltre trent’anni gli effetti delle Radiazioni ionizzanti sul DNA
umano (vedi NACCI 2008 La Minaccia della Centrale atomica di Krsko), a tutt’oggi
non sono ancora giunto a ritenere plausibile un semplice evento naturale concatenato
capace di modificare, quasi come fosse stata una sorta di “Danza Divina” condotta
sul DNA di una Scimmia, una tale serie di modifiche genetiche, senza per altro
determinare instabili Aberrazioni cromosomiche, cromatidiche o sub-cromatidiche.
Ritengo che avesse allora ragione, Albert Einstein, quando affermava che, superata la
difficile Porta della Conoscenza, “…Sottile sembrava essere Dio, ma senza malizia…”.
LEGGI ANCHE: Trasmutazione a basso costo delle scorie radioattive in sostanze non radioattive
GUARDA IL VIDEO: Evoluzione umana, 6 milioni di anni fa in Africa
Biografia dell’Autore.
Giuseppe Nacci nasce a Trieste nel 1964. Laureatosi in Medicina e Chirurgia a Trieste nel 1991, si
specializza successivamente in Medicina Nucleare presso l’Università di Milano. Nel 2000 pubblica
il libro “La Terapia dei Tumori con Gadolinio 159 in Risonanza Magnetica Nucleare”, in vista di
un possibile impiego dell’isotopo radioattivo in Adroterapia, e di cui ottiene il Brevetto di
produzione per la molecola Gadolinio 159-Biotina (No. 01313103).
Ma la Vita è mutevole nei suoi accadimenti, e nel 2001 vicende improvvise e drammatiche lo
costringono a rivedere completamente le proprie cognizioni di MEDICINA, portandolo su un nuovo
e diverso percorso, che lo obbliga a dieci lunghi anni di studio nel campo della BOTANICA, e più
precisamente nell’impiego delle Piante Medicinali FRESCHE per indurre l’Apoptosi nelle cellule
umane tumorali maligne, caratterizzate, come noto, da Aberrazioni cromosomiche (mutazioni
genetiche).
L’esperienza medica sul campo, presso un piccolo ambulatorio privato di Trieste, benchè arricchita
nel 2007 dalla pubblicazione del libro “Diventa Medico di Te Stesso” della “Editoriale Programma”
di Treviso, si conclude nell’Aprile del 2011, quando il dott. Giuseppe Nacci cessa di prendere in
cura pazienti, a seguito dell’entrata in vigore, dal primo Maggio 2011, delle nuove leggi
dell’Unione Europea che proibiscono, da allora, proprio l’uso terapeutico delle Piante Medicinali
FRESCHE.
Rimangono così due libri di questa lunga e sofferta esperienza “sul campo”: “Guariti dal Cancro
senza Chemio: 23 casi clinici documentati di guarigione” e “Cancer Therapy: 23 Clinical Cases of
Malignant Tumours cured without Chemo-Therapy”, entrambi pubblicati dalla “Editoriale
Programma” di Treviso, accanto ad un libro sulla minaccia rappresentata in tutto il mondo dalle
centrali nucleari (“Centrali nucleari: Chernobyl, Krsko, Fukushima. Conoscere il passato per
preservare il futuro”, e un libro sul diabete (“Come affrontare il Diabete”), anche questi pubblicati
presso la “Editoriale Programma” di Treviso.
Dal 2013 riprende i suoi vecchi studi di Geologia, di Astronomia e di Greco antico, che aveva
purtroppo trascurato dopo i tempi del Liceo e dell’Università, affrontando così il grande mistero
dell’ATLANTIDE, analizzato però dal punto di vista scientifico, e di cui è uscito nel 2018, sempre
presso la “Editoriale Programma” di Treviso, il primo dei cinque libri previsti sull’argomento:
“L’Ultima Guerra di Atlantide, Vol. Primo: il Mondo Perduto”, 364 pagg).
Nel Maggio 2020 ha pubblicato il libro Primo Maggio 2011, la lunga Notte (90 pagine), scaricabile
gratuitamente da INTERNET (www.pieronuciari.it/wp/nacci/ ), anche in versione inglese (First
May 2011, the long Night). Altri siti in merito al libro Primo Maggio 2011, la lunga Notte (90
pagine), scaricabile gratuitamente da INTERNET.






